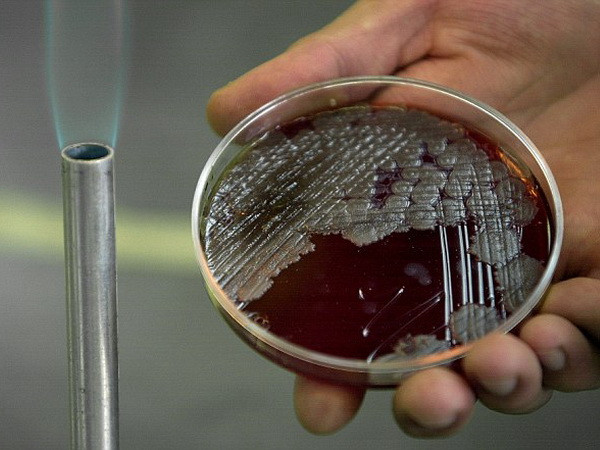
Quân đội Mỹ gửi nhầm mẫu phẩm bệnh than trong nhiều năm qua ảnh 1

Ảnh chỉ có tính minh họa. (Nguồn: AP)
Ảnh chỉ có tính minh họa. (Nguồn: AP)
Trong 10 năm qua, quân đội Mỹ đã chuyển mẫu phẩm bệnh than có nguy cơ gây bệnh tới hàng chục cơ sở trên khắp cả nước cũng như bảy quốc gia khác.
Một báo cáo chính phủ công bố ngày 23/7 cho biết từ năm 2005, đã có tổng cộng 86 phòng thí nghiệm nhận được các mẫu phẩm bệnh than gửi từ Mỹ, bao gồm các cơ sở tại Australia, Anh, Canada, Đức, Italy, Nhật Bản và Hàn Quốc cùng 20 bang của Mỹ và thủ đô Washington.
Theo báo cáo của một ủy ban điều tra thuộc Bộ Quốc phòng, Phòng thí nghiệm Dugway (DPG) của quân đội Mỹ tại bang Utah là cơ sở lớn nhất chuyên sản xuất các mẫu phẩm chứa vi khuẩn bệnh than đã vô được hiệu hóa bằng bức xạ để phục vụ nghiên cứu. Các mẫu phẩm này sau đó được gửi tới những phòng thí nghiệm thương mại và các cơ sở của chính phủ khác.
Tuy nhiên, quy trình thực hiện các bước này tại DPG lại hết sức lỏng lẻo, dẫn tới việc trên thực tế, các mẫu phẩm chứa mầm bệnh than "sống," có thể gây bệnh, đã được chuyển tới các địa chỉ khác trong suốt 10 năm qua.
Các thành viên ủy ban trên kêu gọi xây dựng các tiêu chuẩn thống nhất về tiến trình bức xạ và xét nghiệm sau bức xạ đối với các mẫu phẩm chứa vi khuẩn gây bệnh.
Trước đó, ngày 27/5, Lầu Năm Góc thừa nhận một phòng thí nghiệm quân đội đã gửi nhầm mẫu phẩm bệnh than tới nhiều phòng thí nghiệm ở 19 bang nước này cùng nhiều cơ sở nước ngoài, song khẳng định không có mối đe dọa nào đối với sức khỏe cộng đồng.
Các mẫu bệnh phẩm này đúng ra chứa các vi khuẩn "chết" nhằm phục vụ mục đích nghiên cứu. Tuy nhiên, phòng thí nghiệm tại Maryland thông báo mẫu phẩm họ nhận được chứa các vi khuẩn sống.
Lầu Năm Góc đã ngay lập tức cảnh báo các phòng thí nghiệm và ra lệnh tiêu hủy các mẫu phẩm này. Thứ trưởng Quốc phòng Mỹ Robert Work đã ra lệnh tiến hành một cuộc điều tra về vụ việc.
Hiện không ghi nhận trường hợp nào mắc bệnh nhưng có 31 người đã phải điều trị y tế để phòng ngừa lây nhiễm./.





































